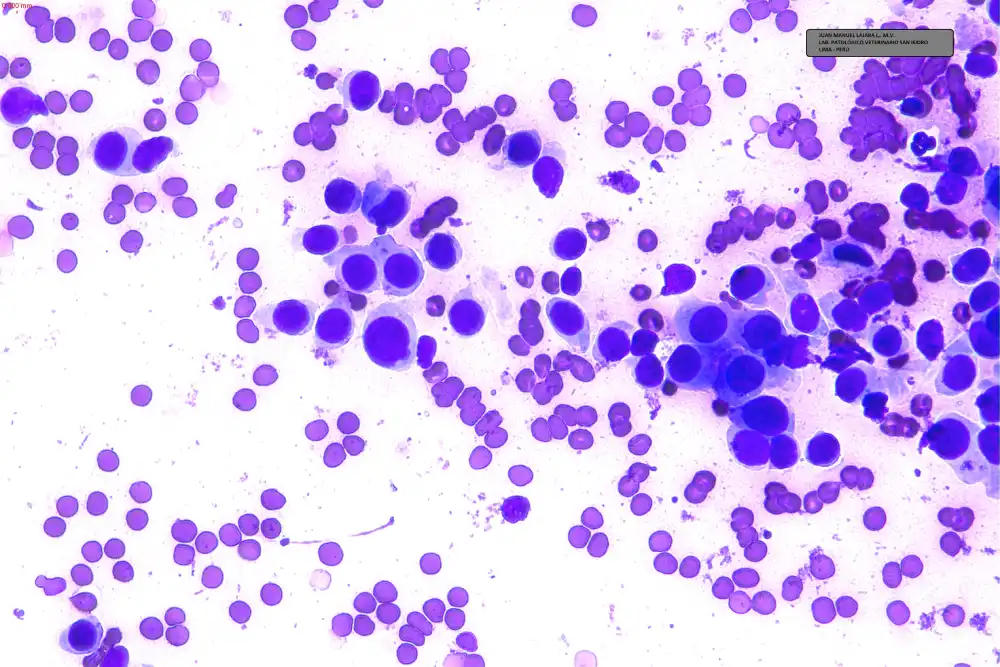

HISTORIA CLÍNICA Y DATOS
Llega a consulta un paciente canino, chihuahua hembra entera de 12 años con una masa de 3 cm (FOTO 1.0) sobre la piel del vientre en la porción inguinal central. La masa se observa irregular no pigmentada, ulcerada de superficie necrótica supurativa, con apariencia intradérmica, de bordes eritematosos y emana un olor desagradable relacionado con contaminación bacteriana. El propietario manifiesta que la masa la percibieron de casualidad hace algunos meses pero en las últimas dos semanas creció a velocidad aumentada.
El paciente mantiene todas sus constantes normales sin cambios en los estudios hematológicos, de bioquímica y uroanálisis.

Se le comenta al propietario que es necesario iniciar la aproximación diagnóstica con un estudio citológico. Se procede a limpiar la herida con una gasa embebida en solución de clorhexidina al 2% para desinfectar la zona de PAF y remover las costras supurativas. Este procedimiento crea mucha incomodidad en el paciente que expresa vocalizaciones y se rehúsa al procedimiento.
Se procede a realizar PAF (Punción con Aguja Fina) utilizando la técnica sin jeringa y con aguja #23 de 1” de longitud en dos puntos distintos de la masa, incidiendo en la zona ulcerada y zona aún cubierta por piel. La muestra es extendida bajo la técnica de squash, colorada con DIFF QUICK y observada al microscopio. (Fotos A 1-4)

FOTO A-1

FOTO A-2
FOTO A-3

FOTO A-4
PREGUNTAS
1. En base a la observación de las microfotografías indique la estirpe celular:
- A. TUMOR DE CÉLULAS REDONDAS
- B. TUMOR DE CÉLULAS EPITELIALES
- C. TUMOR DE CÉLULAS MESENQUIMALES
- D. PROCESO INFLAMATORIO
2. Observe con detenimiento las imágenes citológicas nuevamente e indique su posible diagnóstico:
3. Resolución del Caso, No ingreses aquí sin antes haber pasado por las preguntas anteriores